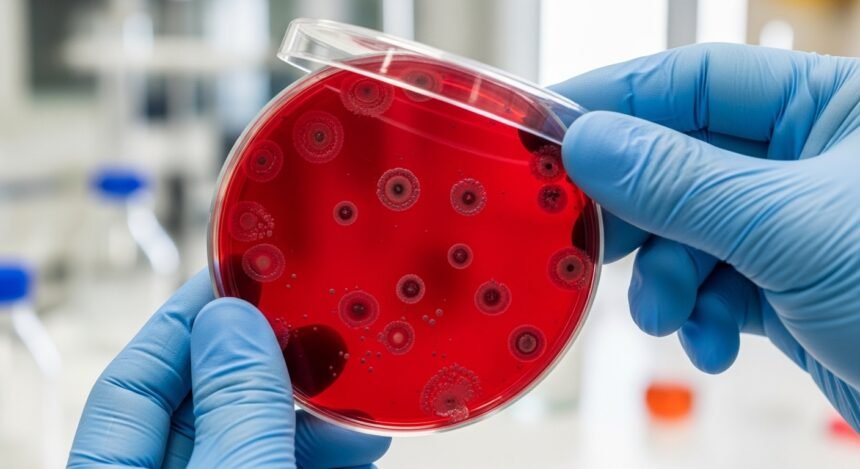

For decades, artemisinin has been the “wonder drug” in the global fight against malaria. As the cornerstone of modern treatment, it has saved millions of lives and significantly reduced the global burden of the disease. However, a silent shadow is creeping across the map of public health: Artemisinin resistance. This phenomenon threatens to undo twenty years of progress, making the most common forms of malaria harder to treat and more dangerous for vulnerable populations.
Understanding the nuances of Artemisinin resistance is not just for scientists in labs; it is vital for travellers, healthcare providers, and policy-makers alike. If we lose the efficacy of these antimalarial drugs, the consequences for global health could be catastrophic.
What Exactly is Artemisinin Resistance?
In the simplest terms, resistance occurs when the malaria parasite, specifically Plasmodium falciparum, no longer responds as effectively to artemisinin-based treatments. It does not necessarily mean the drug fails completely every time, but rather that there is a significant delay in parasite clearance from the patient’s bloodstream.
When the drug takes longer to work, it allows the surviving parasites more time to multiply and spread to the next mosquito that bites the host. According to the World Health Organization, this delay is often linked to genetic changes in the parasite, specifically the Kelch13 mutation, which acts as a molecular marker for resistance.
The Evolution and Spread: From Mekong to Africa
Historically, the “cradle” of drug-resistant malaria has been Southeast Asia, particularly the Greater Mekong subregion. For years, experts watched as resistance emerged in countries like Cambodia and Thailand. However, the most concerning recent development is the confirmed emergence of resistance in Sub-Saharan Africa.
Africa accounts for more than 90% of the world’s malaria cases and deaths. The London School of Hygiene & Tropical Medicine has highlighted that if artemisinin-based treatments fail on a large scale in Africa, we could see a dramatic spike in childhood mortality. The spread of multi-drug resistance makes the situation even more complex, as the parasites become resistant to both artemisinin and the “partner drugs” used alongside it.
How Artemisinin-Based Combination Therapy (ACT) Works
To prevent resistance, artemisinin is rarely used alone. Instead, it is paired with other drugs in a strategy known as ACT therapy. This combination approach aims to kill the majority of parasites quickly with artemisinin, while the partner drug mops up the remaining stragglers.
| ACT Component | Primary Role | Duration of Action |
|---|---|---|
| Artemisinin Derivative | Rapidly reduces the parasite biomass during the first 48 hours. | Short-acting (clears from body quickly). |
| Partner Drug (e.g., Lumefantrine) | Eliminates residual parasites and prevents recurrence. | Long-acting (stays in the blood for days/weeks). |
| The Combination | Provides high therapeutic efficacy and slows resistance. | Synergistic effect. |
Why This is a Major Public Health Threat
The rise of Artemisinin resistance is considered a top-tier public health threat for several reasons:
- Increased Mortality: Delayed treatment response leads to more severe cases of malaria, which are harder to manage and more likely to be fatal.
- Economic Burden: Treating resistant malaria requires more expensive, second-line drugs and longer hospital stays, straining the budgets of developing nations.
- Fragile Progress: Countries that were close to malaria elimination are now seeing a resurgence in cases.
- Limited Alternatives: While new drugs are in development by groups like the Medicines for Malaria Venture, they are not yet available for widespread use.
The NHS Malaria Overview emphasises that for travellers, following WHO guidelines on chemoprophylaxis and early diagnosis is more critical than ever.
Strategies to Combat Resistance
Addressing this challenge requires a multi-faceted approach. It is not just about finding new chemicals, but about better genomic surveillance and smarter vector control.
- Genomic Surveillance: Scientists are using advanced genetic sequencing to track the Kelch13 mutation. This allows health organisations to map where resistance is emerging in real-time.
- Improving Diagnostic Tools: The use of rapid diagnostic tests (RDTs) ensures that patients only receive antimalarial drugs when they actually have malaria, reducing the unnecessary drug pressure that encourages resistance.
- Triple ACTs: Research published in The Lancet Infectious Diseases suggests that using three drugs instead of two (Triple ACTs) may provide a stronger barrier against the evolution of resistant parasites.
- Vector Control: Reducing the mosquito population through insecticide-treated nets and indoor spraying remains a cornerstone of prevention.
Organisations like the Bill & Melinda Gates Foundation and the Wellcome Trust are pouring resources into these innovative strategies to stay one step ahead of the parasite.
The Role of Vaccines
While drugs are facing hurdles, the development of vaccines offers a glimmer of hope. The Gavi, the Vaccine Alliance has been instrumental in the rollout of the RTS,S malaria vaccine. While not 100% effective, vaccines add another layer of protection that does not rely solely on the chemical pathways that the parasite has learned to bypass.

The Future of Malaria Treatment
The road ahead is challenging. As noted by the University of Oxford Malaria Research team, the parasite is a formidable foe that has evolved to survive almost every drug we have thrown at it over the last century. However, through global cooperation and the support of The Global Fund, there is a pathway to containing Artemisinin resistance.
We must prioritise the following:
- Stricter regulation of antimalarial drugs to prevent the sale of counterfeit or sub-standard medicines.
- Increased funding for the discovery of non-artemisinin-based compounds via platforms like ScienceDirect.
- Enhanced education for local communities on the importance of completing the full course of treatment.
If you would like to dive deeper into the technical data, you can explore peer-reviewed studies on Nature or the Malaria Journal, which provide extensive details on parasite genetics and therapeutic efficacy studies. For the general public, staying informed through the CDC Malaria Information pages is a great way to understand the changing landscape of infectious diseases.
Frequently Asked Questions (FAQs)
What happens if I have artemisinin-resistant malaria?
If you are diagnosed with a resistant strain, standard ACTs may take longer to clear the infection. Your doctor may need to adjust the dosage, extend the treatment duration, or switch to an alternative second-line therapy. Monitoring in a clinical setting is usually required to ensure full recovery.
Does this mean artemisinin no longer works?
No, artemisinin is still highly effective in most parts of the world. “Resistance” in this context usually refers to a “partial resistance” where the drug works more slowly. It is still a vital tool, but its decreasing effectiveness in certain regions is a warning sign that we need new strategies.
How can I protect myself when travelling to areas with resistance?
The best protection is prevention. Use high-quality insect repellent, sleep under insecticide-treated bed nets, and strictly follow the malaria prophylaxis prescribed by your travel clinic. If you develop a fever after returning from a malaria-endemic area, seek medical attention immediately and inform the clinician of your travel history.
Is the Kelch13 mutation the only cause of resistance?
While the Kelch13 mutation is the primary marker used for genomic surveillance, resistance is a complex biological process. Other genetic factors and the parasite’s ability to enter a “dormant” state to survive drug exposure are also being studied by researchers globally.